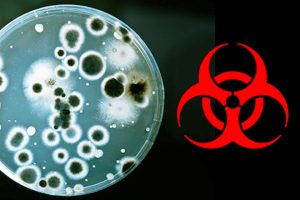
Biological-Weapons

Category: Environment
Mobitel & Thuru’s reforestation project shortlisted at GSMA Global Mobile Awards 2020
Mobitel and Thuru’s joint project – ‘Reforestation through Technology’ – has been shortlisted for the ‘Best Mobile Innovation for Climate Action award’ at GSMA Global Mobile Awards 2020, popularly known as the GLOMO Awards, scheduled to be held in Barcelona in February 2020, where winners will be announced. This recognition is yet another feather in the cap […]
Stax creates roadmap to fixing bad air quality
In November 2019, the US embassy’s Air Quality monitor in Colombo registered a value of 167, whereas the accepted value of air quality stands at 50. Even though the figures fluctuate as of February 2020, the current air quality index is yet at 97 – almost twice the recommended figure. While this issue has been […]
Planters’ Association urges policy makers to make final decision on oil palm cultivation
Jan 17, 2020 (LBO) – Planters’ Association of Ceylon urges policy makers to urgently convene a meeting of all stakeholders in order to make a final determination on the subject of oil palm cultivation in Sri Lanka, after having fully considered all available and verified scientific and economic data on the subject. Full Statement Sri […]
Cabinet nod to increase estate worker daily wage to 1,000 rupees
Jan 15, 2020 (LBO) – Sri Lanka’s Cabinet of Ministers have decided that the minimum daily wage of estate workers to be 1,000 rupees with effect from March this year. It was also decided to take swift measures to develop all areas of the plantation sector including infrastructure facilities. The cabinet proposal tabled by the […]
Global initiative by FAO to control Fall Armyworm; mobile app to launch in local languages
Dec 16, 2019 (LBO) – The Food and Agriculture Organization of the United Nations (FAO) has launched a pioneering initiative – “Global Action for Fall Armyworm Control”, that aims to mobilize USD 500 million over 2020–22 to take radical, direct and coordinated measures to fight Fall Armyworm at a global level. In Sri Lanka, FAO […]
Sri Lanka to benefit from US “Clean Cities, Blue Oceans” global initiative
Dec 12, 2019 (LBO) – The United States Agency for International Development (USAID), On December 5, launched its “Clean Cities, Blue Ocean” (CCBO) program in Sri Lanka and the Maldives, the most recent countries to join this flagship initiative to mitigate ocean plastic. CCBO is a 48 million dollar, a five-year global initiative that helps […]
Sri Lanka elected Chair of Biological Weapons Convention Meet
Dec 09, 2019 (LBO) – The Meeting of States Parties (MSP) to the Convention on Biological Weapons, which concluded its four-day session in Geneva today unanimously endorsed Sri Lanka as the Chair of the Meeting of States Parties to be held in 2020. Sri Lanka’s Permanent Representative to the UN in Geneva Ambassador A.L.A. Azeez […]
Sri Lanka bans import of spices, minor export crops for re-export
Dec 06, 2019 (LBO) – Sri Lanka’s Finance Ministry has prohibited the importation of spices and minor export crops for the purpose of re-export or re-export after minor processing. The Finance Ministry said in a statement that this restriction has been imposed as a measure to protect small export crop growers and SMEs. Accordingly, the […]
United States supports Sri Lankan efforts to reduce landslide risk
The United States donated landslide monitoring instruments to Sri Lanka’s National Building Research Organization (NBRO) to more effectively manage the risk of landslides in Nikgaha, Kalutara. As part of the initiative, engineers and geologists from the U.S. Geological Survey (USGS) visited Sri Lanka from November 5 to 15 to partner with Sri Lanka’s scientists on […]
Sri Lankan spices & other products to benefit from Geographical Indications
Nov 06, 2019 (LBO) – The Food and Agriculture Organization of the United Nations (FAO) and the Ministry of Primary Industries and Social Empowerment of Sri Lanka have launched a project aiming to establish a national system for Geographical Indications (GIs). GIs help consumers identify food and other products originating in a particular geographical location, […]
Sri Lanka unveils first bamboo energy forum with UNIDO backing
Oct 23, 2019 (LBO) – United Nations Industrial Development Organization (UNIDO) is collaboratively unveiling Sri Lanka’s first forum on bamboo for energy and industrial sustainability. The forum, organized by UNIDO in collaboration with the Institution of Engineers of Sri Lanka (IESL), takes place on Friday, October 25 at the Institution of Engineers Sri Lanka (IESL), […]
PA sounds alarm on growing discrepancy between tea auction & export prices
Oct 21, 2019 (LBO) – The Planters’ Association of Ceylon sounded a cautionary note with regard to the health and sustainability of the entire tea industry – including Regional Plantation Companies (RPC), and Government and smallholder sectors at large – as tea and rubber prices at the Colombo auction continuously plummeted in 2019. Releasing a […]